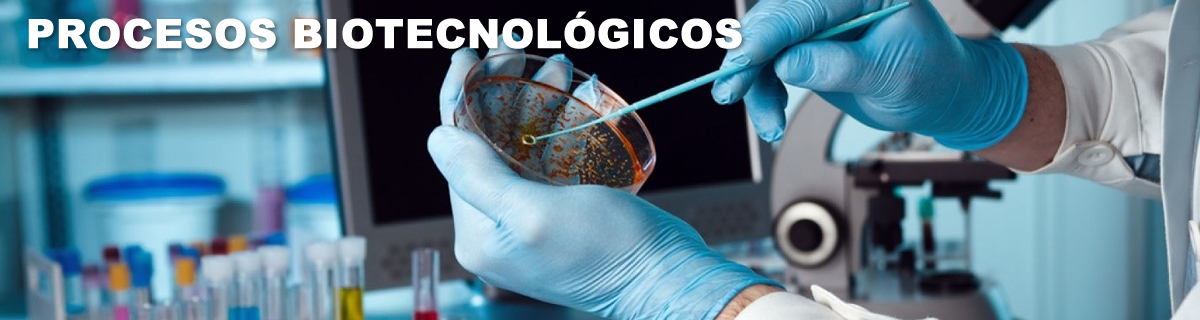
Procesos químicos, físicos y biotecnológicos

Presentación
Apreciada comunidad académica, tenemos el gusto de invitarlos al Congreso Internacional de Ingeniería con Impacto Social. Evento que se llevará a cabo en las instalaciones de la Universidad Cooperativa de Colombia en la ciudad de Medellín (Bloque 1, sede centro), los días 5 y 6 de septiembre del año en curso.
Este evento busca ser el espacio de encuentro para visibilizar el impacto social derivado de la integración de las distintas ramas de la ingeniería, así como la importancia de la investigación en la ingeniería para el desarrollo del país. En este sentido, el Congreso se concibe como un espacio que permitirá la comunicación y la discusión entre las Universidades, las entidades estatales y las empresas, con el fin de generar reflexiones en torno al papel de la ingeniería, los proyectos de innovación y el desarrollo tecnológico con miras al mejoramiento de la calidad de vida de nuestras comunidades y la sociedad en general.
Así, la Universidad Cooperativa de Colombia Seccional Medellín quiere convocar a las instituciones de educación superior, centros de investigación, al sector industrial y productivo, a las entidades públicas y privadas y a la comunidad en general a vincularse a este evento y a participar con aquellos aportes que a través de la ingeniería apunten a la búsqueda de soluciones y a contribuir con el desarrollo de la sociedad.
Con el propósito de acoger las diversas áreas de investigación en ingeniería, en el Congreso se han concebido 4 grandes líneas temáticas:
1. Energía, Agua y Medio Ambiente
En esta línea se abordarán los proyectos de generación energética con fuentes tradicionales y alternativas, así como los estudios en el cuidado y calidad del agua y el medio ambiente.
2. Materiales, Procesos Químicos, Físicos y Biotecnológicos
Se considerarán aquí los desarrollos en materiales novedosos y amigables con el ambiente, y los procesos de generación y transformación de recursos, productos e insumos a través del modelamiento y diseño de procesos especializados.
3. 4ª Revolución Industrial y Tecnologías de la Información y la Comunicación (TIC)
Apuntando a la revisión de las propuestas en administración de los recursos y medios tecnológicos, la implementación de tecnologías informáticas y de las comunicaciones con miras a el establecimiento de ciudades y entornos más inteligentes.
4. Estructuras, Vías y Transporte
Donde se evidenciarán los estudios que buscan impactar los proyectos de desarrollo de la infraestructura civil a nivel de los territorios y las comunidades.
Convoca y Organiza

Grupo de investigación TERMOMEC de la Facultad de Ingenierías - Medellín.
Organizan
 |
 |
 |
|
|
|
|
 |
 |
 |
 |
|
 |
Apoyan
 |
 |
 |
 |
 |
Patrocinan
 |
 |
 |